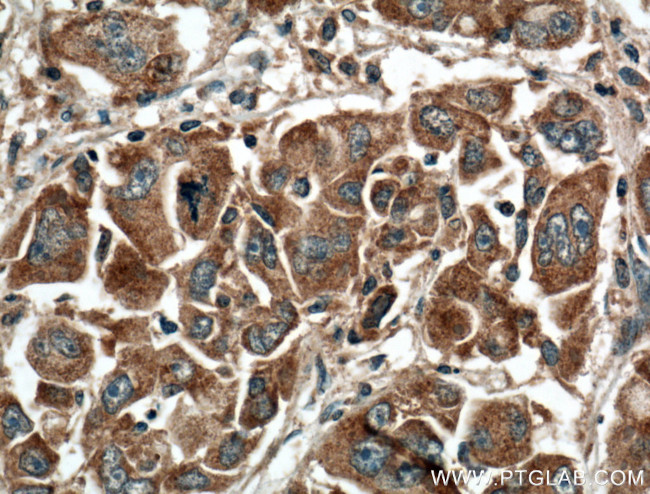
GNPAT Antibody in Immunohistochemistry (Paraffin) (IHC (P))
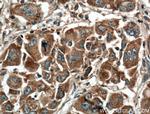
GNPAT Antibody in Immunohistochemistry (Paraffin) (IHC (P))

Search
Proteintech
GNPAT Monoclonal Antibody (2E5C10)
{{$productOrderCtrl.translations['antibody.pdp.commerceCard.promotion.promotions']}}
{{$productOrderCtrl.translations['antibody.pdp.commerceCard.promotion.viewpromo']}}
{{$productOrderCtrl.translations['antibody.pdp.commerceCard.promotion.promocode']}}: {{promo.promoCode}} {{promo.promoTitle}} {{promo.promoDescription}}. {{$productOrderCtrl.translations['antibody.pdp.commerceCard.promotion.learnmore']}}
产品信息
66453-1-IG
种属反应
宿主/亚型
分类
类型
克隆号
抗原
偶联物
形式
浓度
纯化类型
保存液
内含物
保存条件
运输条件
产品详细信息
This antibody recognize the 65-69 kDa GNPAT protein.
Immunogen sequence: PVSLRSLAA GRMSRSSYNL VPRYIPQKQS EDMHAFVTEV AYKMELLQIE NMVLSPWTLI VAVLLQNRPS MDFDALVEKT LWLKGLTQAF GGFLIWPDNK PAEEVVPASI LLHSNIASLV KDQVILKVDS GDSEVVDGLM LQHITLLMCS AYRNQLLNIF VRPSLVAVAL QMTPGFRKED VYSCFRFLRD VFADEFIFLP GNTLKDFEEG CYLLCKSEAI QVTTKDILVT EKGNTVLEFL VGLFKPFVES YQIICKHLLS EEEDHFSEEQ YLAAVRKFTS QLLDQGTSQC YDVLSSDVQK NALAACVRLG VVEKKKINNN CIFNVNEPAT TKLEEMLGCK TPIGKPATAK L (331-680 aa encoded by BC000450)
靶标信息
GNPAT is a key enzyme located in the peroxisomal membrane which is essential to the synthesis of ether phospholipids. Mutations in GNPAT are associated with rhizomelic chondrodysplasia punctata type 2, which is characterized by rhizomelic shortening of femur and humerus, vertebral disorders, cataract, cutaneous lesions and severe mental retardation.
仅用于科研。不用于诊断过程。未经明确授权不得转售。
篇参考文献 (0)
生物信息学
蛋白别名: Acyl-CoA:dihydroxyacetonephosphateacyltransferase; DAP-AT; DHAP-AT; Dihydroxyacetone phosphate acyltransferase; Glycerone-phosphate O-acyltransferase
基因别名: DAP-AT; DAPAT; DHAPAT; GNPAT; RCDP2
UniProt ID: (Human) O15228
Entrez Gene ID: (Human) 8443